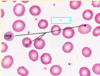
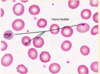

A patient’s investigations reveal pancytopenia and macrocytosis. His peripheral smear shows hyper-segmented neutrophils. Serological tests reveal positive anti intrinsic factor antibodies. What other biochemical derangements might be observed in this patient?
A. Increased plasma metanephrines
B. Elevated ferritin levels
C. Increased urinary 5-hydroxytryptamine
D. Elevated plasma homocysteine
A patient’s investigations reveal pancytopenia and macrocytosis. His peripheral smear shows hyper-segmented neutrophils. Serological tests reveal positive anti intrinsic factor antibodies. What other biochemical derangements might be observed in this patient?
D. Elevated plasma homocysteine
This patient likely has megaloblastic anemia due to a deficiency of vitamin B12. Vitamin B12 is an essential co-factor involved in two important enzymes. One of these enzymes is methionine synthase, which converts homocysteine to methionine. The deficiency of cobalamin will lead to the impaired functioning of this enzyme. This will result in an accumulation of homocysteine which can be detected in the blood.
Which is the most common?
ASD
VSD
PDA
Coarctation of the aorta
Which is the most common?
ASD
VSD
PDA
Coarctation of the aorta
Explain what bundle branch block is [1]
Which part of ECG can see bundle branch block occur in? [1]
Explain what bundle branch block is [1]
Disruption to the electrical signal that causes your heart to beat [0.5]
Causes altered pathways for depolarisation [0.5]
Which part of ECG can see bundle branch block occur in? [1]
Prolongs QRS

Which views of the heart are seen by each type of ECG lead on a standard 12-lead ECG? [4]
- *S**eptal: V1, V2
- *A**nterior: V3, V4
- *L**ateral: V5, V6, AVL, I
- *I**nferior: II, III, AVF
AVR: neutral

What is concentric hypertrophy characterised by visually? [1]
How does concentric hypertrophy occur? [1]
When does concentric hypertrophy occur? [2]
What does concentric hypertrophy cause to happen and why? [1]
What is concentric hypertrophy characterised by visually? [1]
- Increased wall thickness / reduced lumen of ventricle
How does concentric hypertrophy occur? [1]
- New sarcomeres produced
When does concentric hypertrophy occur? [1]
- Aortic stenosis
- Chronic hypertension
What does concentric hypertrophy cause to happen and why? [1]
- Decreases pre-load due to reduction in compliance (stiff)

Eccentric hypertrophy:
- Caused by? [4]
- Characterised by? [2]
Eccentric hypertrophy:
Caused by? [1]
- Aortic and mitral regurgitation
- Systolic dysfunction (loss of cardiac inotrophy
- -Volume overload (hypervolaemia due to ventricular or renal failure)
- Alcohol / cocaine
Characterised by? [2]
- Chamber dilation - lumen gets bigger, wall gets smaller: cant contract properly

Which of the following forms the right ventricle?
Truncus ateriosus Bulbus cordis Sinus venosus Primitive ventricle Primitive atria
Which of the following forms the right ventricle?
Truncus ateriosus **Bulbus cordis** Sinus venosus Primitive ventricle Primitive atria
Which of the following forms the ventricular outflow tracts?
Truncus ateriosus Bulbus cordis Sinus venosus Primitive ventricle Primitive atria
Which of the following forms the ventricular outflow tracts?
Truncus ateriosus **Bulbus cordis** Sinus venosus Primitive ventricle Primitive atria
Label this xx


Tetralogy of Fallot is comprimised of which 4 heart defects/
- Ventricular septal defect
- Overriding Aorta: aorta is positioned above the VSD
- Pulmonary stenosis (narrowing)
- Right ventricular hypertrophy

What is persistant truncus arteriosus? [2]
Spiral structure doesn’t form in truncus arteriosus: one common outflow tract. Both L & R ventricle pump into same outflow tract [1]
A large VSD (ventricular septal defect) below the truncal valve allows mixing of right and left ventricular blood [1]

Which structures of the heart are formed from the bulbus cordis?
The smooth outfow of the left and right ventricles. The muscular right ventricle. The muscular intraventricular septum.

Which complications are associated with a patent truncus arteriosus?
A large ventricular septal defect. Progressive heart failure. Degree of cyanosis is variable.
How would you ID acute myeloid leukemia? (AML)
- A heterogeneous population of myeloblasts with cells ranging from small to medium-sized to large. Note presence of a few maturing myeloid elements.
- Large myeloblasts with prominent nucleoli. Maturing myeloid elements i.e. neutrophils or eosinophils.

How would you ID chronic lymphocytic leukemia (CLL) from PBS and BMS?
- PBS: Mature-appearing lymphocytes with high nuclear to cytoplasmic ratios, with scant agranular cytoplasm and homogeneously condensed chromatin without nucleoli. Characteristic “soccer ball’ chromatin pattern. Numerous smudge cells
- BMS: tissue is displaced by nodular and interstitial aggregates of clonal B cells.

How would you ID chronic myeloid leukemia (CML) from PBS and BMS?
PBS: > 100K white blood cells with neutrophilia, significant increase in metamyelocytes and myelocytes, also basophilia and eosinophilia
BMS: increased granulocyte precursors, basophils, eosinophils and occasionally monocytes
Normal erythroid compartment, variable pseudo Gaucher cells and sea blue histiocytes, increased reticulin fibres

Describe the process of migration of neutrophils through
Process of migration:
- chemokines picked up by receptors on the neutrophils
– causes intercellular signals to get more & more neutrophils
- cause selectins (which are present on endothelial cells) and attach – endo. cells open and and squeeze through to allow enter area of inflammation

What is shown here?

Kerley B Lines
These are thin lines, often of no more than a couple of centimetres often found towards the base and peripheral regions of the lung where the interstitial has thickened. They lie at 90o to the pleura. On the image, some of these lines are present towards the base of the right lung.

What condition is shown here?

Upper Lobe Blood Diversion
Due to the increased pressures, blood is pushed upwards creating a ‘stag antler’ appearance. Blood is diverted as fluid is more likely to build up lower down due to gravity and cause relative hypoxia and vasoconstriction, thus the blood is diverted to the upper zones.
In the midline of this film, we can also see several sternal sutures.

Explain the mechanism of iron absorbtion and transport in the body for haem iron and non haem iron
Haem iron
- Haem iron – (highly bioavailable) absorbed through DMT1
- Fe removed from Haem. Can then be stored as ferritin OR can exit cell through Ferroportin
Non-haem iron:
- Mostly in the form of Fe3+, but only Fe2+ can be absorbed by the enterocyte. Enzyme reductase: Fe3+ à Fe2+
- Enters via DMT1
- Fe removed from Haem. Can then be stored as ferritin OR can exit cell through Ferroportin
Then transferrin transports Fe3+ around body

What is the first committed cell in erythropeoisis? [1]
What is the pathway from Haematopoietic stem cell (HPSCs) - to erythrocyte? [1]
What is the first committed cell in erythropeoisis? [1]
Proerythroblast
Haematopoietic stem cell (HPSCs) –> common myeloid progenitor cell –> (CMPC)Proerythroblast –> erythroblast –> reticulocyte – > erythocyte

The proerythroblast develops into an (early) erythroblast. The erythroblast then undergoes a sequence of changes where its nucleus progressively shrinks and its cytoplasm becomes filled with haemoglobin (not stained). When full of haemoglobin it is called a normoblast. The normoblast then expels its nucleus and becomes a reticulocyte. Most reticulocytes stay in the marrow and mature into erythrocytes but some may be released into the blood, especially after haemorrhage. Reticulocytes can transport oxygen, just not as efficiently as mature erythrocytes. They can mature into adult RBCs in the circulation
Explain the mechanism of how Fe is recylced during rbc breakdown?
Explain the mechanism of how Fe is recylced during rbc breakdown?
splenic macrophages break down old rbc, via action of haem oxygenase.
Fe3+enters circulation carried ontransferrinto be re-used and exits viaferroportin
What are specific signs associated with anaemia of iron deficiency? [2]
What are specific signs associated with anaemia of vit. B12 deficiency? [1]
What are specific signs associated with anaemia of thelessasmia? [1]
What are specific signs associated with iron deficiency? [2]
- Koilonychia (spoon shaped nails)
- Angular stomatitis (inflammation of corners of mouth)
What are specific signs associated with anaemia of vit. B12 deficiency? [1]
Glossitis (inflammation of tongue)
What are specific signs associated with anaemia of thelessasmia? [1]
abnormal bone facial development

What is anaemia of inflammation / chronic disease caused by? [3]
Why will iron supplementation not help in patients with this condition?
What is anaemia of inflammation?
IL-6 released and causes:
* more hepcidin: which blocks release of Fe2+ out of via ferroportin
* blocks production of EPO (& therefore rbc production)
* inhibits production of rbc in bone marrow
Why will iron supplementation not help in patients with this condition?
Problem is with iron being absorbed in gut and iron getting out of macrophages, along with depressed erythropoietin release and erythropoiesis caused by inflammatory cytokines – need to treat cause inflammation